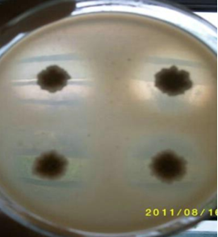
1554185282972191.png image.png

Bacillus Subtilis
Bacillus subtilis is a Gram-positive, aerobic, spore-forming bacterium. After ingested, the spores of Bacillus subtilis will
germinate, multiply, temporarily colonize in the upper digestive tract execute excellent positive effect.
Mode of action of GBW Bacillus Subtilis:

① Secretion of digestion enzyme ② Inhibition of pathogen adhesion and colonization
③ Production of antibacterial substances ④ Maintain intestinal integrity
⑤ Consumption of oxygen create anaerobic intestinal environment ⑥ Boost immunity
Main functions:
1. Secret Xylanase, protease, and amylase, increase the growth performance and improve feed conversion ratio
2. Favor the environment of Lactobacilli and other lactic acid producing bacteria by creating a positive anaerobic environment
3. Reducing the colonization of E.coli, Salmonella, Clostridium perfringens and other pathogen by Competitive exclusion and
secreting of bacteriocin, prevents enteric disease
4. Enhance immunity, reduce use of antibiotics and maintain animal health
5. Improve the quality of animal products such as meat, eggs, and milk
6. Secret enzyme that can degrade ammonia and H2S, reduce noxious gas emission
GBW Bacillus subtilis has high survival rate
1. When being processed in the feed-milling procedure
2. In the highly acidic and bile upper gastro-intestinal tract
3. During enzymatic digestion

GBW Bacillus subtilis was placed in a solution with a pH of 2.0 and a pepsin concentration of 0.32%, treated at 39 °C
for different time to detect survival rate of Bacillus subtilis.

Result analysis: after pelleting under 85℃, 0.45MPb, the survival rate of GBW Bacillus subtilis is above 92%.

GBW Bacillus subtilis was placed in a solution with a pH of 2.0 and bile concentration of 4mg/L, treated at 39°C for 1 hour
to detect survival rate of Bacillus subtilis.
High germination rate

Sixty broiler in 30 day old were divided into four group, one group is supplement with 100 g (2 million CFU/g) GBW Bacillus
subtilis, the other three group were supplement with 100 g (2 million CFU/g) Bacillus subtilis from other company. 1.5h after
supplement, the Germination rate of Bacillus subtilis in duodenum were tested.
Excellent enzyme-secretion ability
The enzyme activity of xylanase produced by the single colony cultivated in medium for 24h is 300 U/g.
Components: Bacillus subtilis, Carrier
Guaranteed value: 20 billion CFU/g
Usage and dosage: Add 100-150g (20 billion CFU/g) to per ton complete feed
Package and storage:
Keep in cool, dry and shady conditions and seal the bag when it’s not in use, and shelf life is 12 months in original package under 25℃.
25kg/bag.